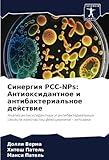
Синергия PCC-NPs: Антиоксидантное и антибактериальное действие: Анализ антиоксидантных и антибактериальных свойств наночастиц фикоцианина - хитозана

La espirulina es un superalimento que ha ganado popularidad en los últimos años gracias a sus increíbles beneficios para la salud. Este alga verde azulada, rica en nutrientes y antioxidantes, se considera uno de los alimentos más completos y nutritivos que podemos incorporar a nuestra dieta diaria.
En el mundo de la parafarmacia, la espirulina se ha convertido en un producto estrella debido a sus propiedades revitalizantes, desintoxicantes y energizantes. Su alto contenido de proteínas, vitaminas, minerales y ácidos grasos esenciales la convierten en una excelente opción para complementar nuestra alimentación y mejorar nuestra salud de forma natural.
En este artículo de Farmaoclock, te presentamos una completa comparativa de las mejores marcas de espirulina disponibles en el mercado, analizando su calidad, pureza, origen y beneficios para que puedas elegir la opción que mejor se adapte a tus necesidades y objetivos de salud. Descubre todo lo que necesitas saber sobre este superalimento y aprovecha al máximo sus propiedades para cuidar tu bienestar de manera efectiva.
Los beneficios de la spirulina en la parafarmacia: ¿Cuál es la mejor opción para ti?
Los beneficios de la spirulina en la parafarmacia:
La spirulina es un suplemento nutricional muy popular por sus múltiples beneficios para la salud. Entre las propiedades destacadas de la spirulina se encuentran su alto contenido en proteínas, vitaminas, minerales y antioxidantes.
En el contexto de la parafarmacia, la spirulina suele estar disponible en distintas presentaciones, como cápsulas, comprimidos o polvo, lo que facilita su consumo según las preferencias de cada persona.
A la hora de elegir la mejor opción de spirulina para ti, es importante tener en cuenta la calidad del producto, su procedencia, los ingredientes adicionales que pueda contener y las recomendaciones de uso. Por ello, te recomendamos analizar detenidamente las etiquetas y buscar productos certificados que garanticen su pureza y eficacia.
Más información
¿Cuál es la concentración de спирулина en los productos de parafarmacia más recomendados?
La concentración de espirulina en los productos de parafarmacia más recomendados varía entre el 60% y 70%.
¿En qué presentaciones se encuentra disponible la спирулина en los productos de parafarmacia analizados?
La спирулина se encuentra disponible en productos de parafarmacia analizados en cápsulas, comprimidos y polvo.
¿Cuál es la calidad y origen de la спирулина utilizada en los productos de parafarmacia mejor valorados?
La спирулина utilizada en los productos de parafarmacia mejor valorados suele ser de alta calidad y de origen orgánico.
En conclusión, la спирулина se presenta como un producto altamente beneficioso para la salud, gracias a sus propiedades nutritivas y antioxidantes. Su consumo regular puede aportar grandes beneficios para nuestro organismo, especialmente en términos de energía, vitalidad y fortalecimiento del sistema inmunológico. A la hora de elegir un producto de спирулиna, es importante considerar su procedencia, calidad y forma de presentación para garantizar su efectividad. ¡Incorpora este superalimento a tu dieta y disfruta de sus múltiples ventajas para tu salud!
- Нджоондо, Гильдас Перфект (Autor)
- Правина, Б. (Autor)
- Дурга Шриниваса Мурти, Систла (Autor)
- Андон Самоходов (Autor)
- Ронда, Шриниваса Редди (Autor)